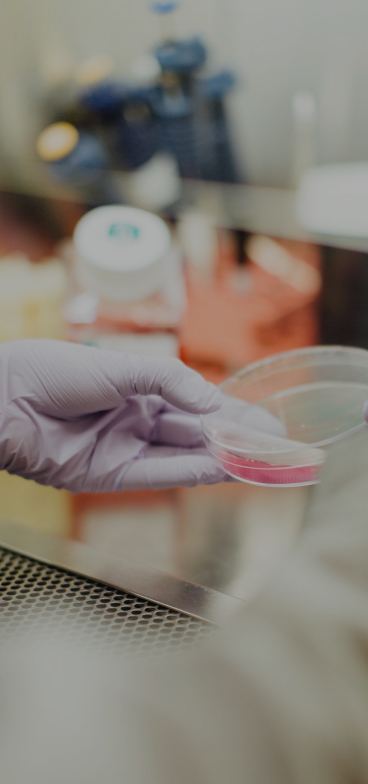

Is established in 2009 for development of functional materials in variable business area. It strengthens specialty by investing advanced lab equipment and by hiring polymer professionals.
We do our best to retain sustainable growth engine, to pursue continuous improvement, and to maximize the value of our customers.

Develop innovative products to create unique value

Establish efficient process for development to optimize its quality and speed

Synchronize the needs of customer
Intensify the depth of humanresource and creative environment for development